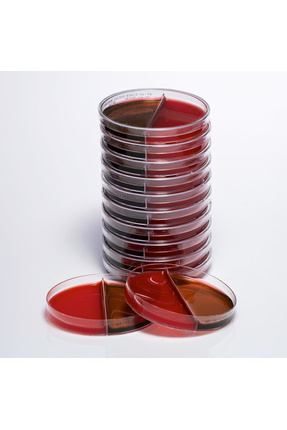
Product

Hazır Koyun Kanlı + EMB Besiyeri - 1 Paket (10 Adet) Hazır Koyun Kanlı + EMB Besiyeri - 1 Paket (10 Adet) MDX - 201 تک سایز
سایت مرجع :
ترندیول
فروشنده:
Medexia Sağlık Hizmetleri
امتیاز فروشنده:
9.1
زمان تحویل در ترکبه:
5 روز
قیمت:
1,496,880تومان

 ورود | ثبت نام
ورود | ثبت نام

نظرات کاربران ترندیول